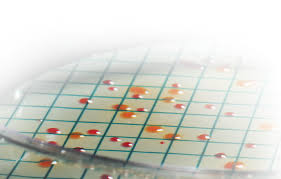

Dominant representatives can carry out staff training for you to assist in accreditation.
Training modules include the following:
- Food Safety & Hygiene
- Safe & Effective use of Cleaning Chemicals
An assessment component is available for all training modules